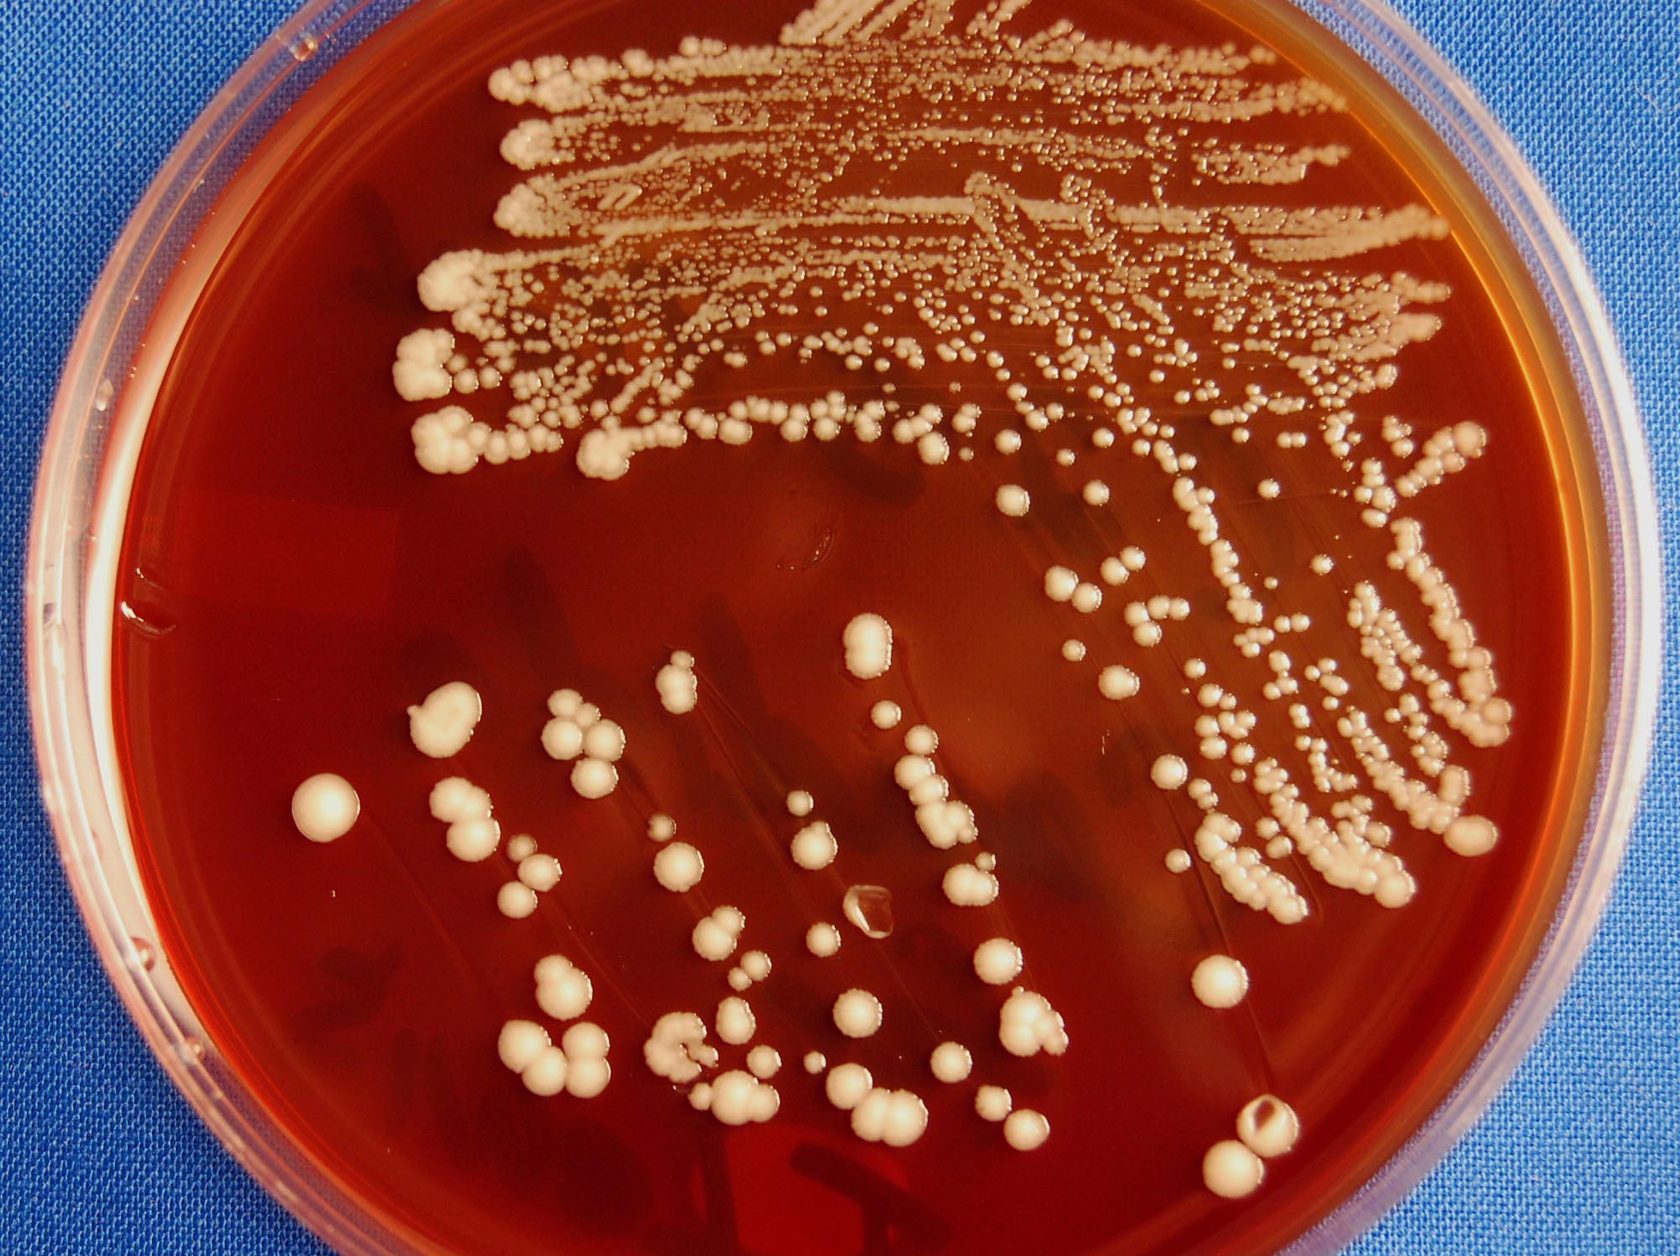

ЗДОРОВЬЕ НА ОТЛИЧНО
Молодость: опять в 25!

УБИВАЮЩИЙ НАС ГРИБОК
Отвечаем на самые популярные вопросы!
Нам поступает огромное количество вопросов про грибок Candida, мы выбрали самые частые и попросили ответить на них дипломированного врача, сертифицированного диетолога, профессионального генетика и лучшего специалиста по женскому здоровью - Елену Бахтину.
ПОЧЕМУ КАНДИДОЗ ОПАСЕН ДЛЯ ВСЕГО ОРГАНИЗМА?
Дрожжи - грибковые паразиты, и бактерия Candida Albicans является среди всех их самой опасной! Она появляется у каждого из нас еще в младенчестве, и мы может не чувствовать никаких проблем, пока для однажды для нее не появятся условия, при которых грибок начинает активно размножаться.
Многие ошибочно считают, что кандидоз - это не более чем "молочница" у женщин - совсем нет! В кишечнике находится 80% микроорганизмов, которые отвечают за наш иммунитет, и если Candida его захватит, то начнутся катастрофические проблемы со здоровьем.
Грибы состоят из мицелия и буквально пускают корни в стенки кишечника, выбрасывая в ткани продукты своей жизнедеятельности - токсичные вещества. Врачи считают, что примерно треть ВСЕХ ЗАБОЛЕВАНИЙ - результат разбушевавшейся Candida!
У нас могут быть проблемы с этим грибком, если есть такие симптомы:
ЧЕМ ПИТАЕТСЯ ОПАСНАЯ Candida?
Этот грибок просто обожает сахар во всех его проявлениях! Он просто невероятный стимулятор, благодаря которому кандида может очень быстро захватить кишечник и распространиться по всему организму, разрушая его, замещая собой необходимые нам бактерии.
Хотите избавиться от токсичной Candida - в первую очередь исключите из рациона сахар!
Если вы сладкоежка, то подумайте, может быть, причиной такой тяги является этот грибок, который постоянно хочет сладкого и посылает сигналы вам, вызывая желание его подкармливать снова и снова?
Представляете себе - когда у вас в крови резко поднимается уровень сахара, организм использует использует бактерию Candida для усвоения этого избытка!
Получается, что практически с рождения мы буквально "заминированы" грибком Candida Albicans, и стоит только активировать его сахаром, он начинает взрывоопасные процессы. Может быть, тогда не стоит курить, сидя на бочке с порохом, которая стоит в луже бензина?..
ПОЧЕМУ КАНДИДОЗ ОПАСЕН ДЛЯ ВСЕГО ОРГАНИЗМА?
Дрожжи - грибковые паразиты, и бактерия Candida Albicans является среди всех их самой опасной! Она появляется у каждого из нас еще в младенчестве, и мы может не чувствовать никаких проблем, пока для однажды для нее не появятся условия, при которых грибок начинает активно размножаться.
Многие ошибочно считают, что кандидоз - это не более чем "молочница" у женщин - совсем нет! В кишечнике находится 80% микроорганизмов, которые отвечают за наш иммунитет, и если Candida его захватит, то начнутся катастрофические проблемы со здоровьем.
Грибы состоят из мицелия и буквально пускают корни в стенки кишечника, выбрасывая в ткани продукты своей жизнедеятельности - токсичные вещества. Врачи считают, что примерно треть ВСЕХ ЗАБОЛЕВАНИЙ - результат разбушевавшейся Candida!
У нас могут быть проблемы с этим грибком, если есть такие симптомы:
- синдром хронической усталости
- проблемы с расщеплением пищи
- нарушение гормонального баланса
- аллергия
- падение иммунитета
- боли в суставах
- проблемы мочеполовой сферы
- фибромиалгя
- гипогликемия
ЧЕМ ПИТАЕТСЯ ОПАСНАЯ Candida?
Этот грибок просто обожает сахар во всех его проявлениях! Он просто невероятный стимулятор, благодаря которому кандида может очень быстро захватить кишечник и распространиться по всему организму, разрушая его, замещая собой необходимые нам бактерии.
Хотите избавиться от токсичной Candida - в первую очередь исключите из рациона сахар!
Если вы сладкоежка, то подумайте, может быть, причиной такой тяги является этот грибок, который постоянно хочет сладкого и посылает сигналы вам, вызывая желание его подкармливать снова и снова?
Представляете себе - когда у вас в крови резко поднимается уровень сахара, организм использует использует бактерию Candida для усвоения этого избытка!
Получается, что практически с рождения мы буквально "заминированы" грибком Candida Albicans, и стоит только активировать его сахаром, он начинает взрывоопасные процессы. Может быть, тогда не стоит курить, сидя на бочке с порохом, которая стоит в луже бензина?..
СИНДРОМ ДЫРЯВОГО КИШЕЧНИКА - ЧТО ЭТО?
Если вы едите много сладкого, скорее всего, у вас уже есть синдром дырявого кишечника. Чувствуете симптомы авитаминоза? Можно сказать почти с уверенность, что грибок захватил и продырявил ваш кишечник.
Если у вас в кишечнике живет разбушевавшаяся кандида, вы можете вести любой, самый здоровый, образ жизни, заниматься спортом, питаться идеально подобранным меню, но… ничего у вас не усвоится и тело будет страдать.
Что может быть хорошего, если Candida разрастается на стенках кишечника? Она буравит их, проедает, попадает в вашу кровь, разносится по всему организму.
Более того! Вместе с ней через повреждения в кровоток могут попадать и другие вещества. И, естественно, иммунная система начнет атаковать это, вызывая аутоиммунные заболевания.
Поэтому, если у вас аллергия, подумайте, нет ли у вас кандидоза?
ПОЧЕМУ ГОВОРЯТ, ЧТО ЭТОТ ГРИБОК ВЫЗЫВАЕТ ДЕПРЕССИЮ?
...А также панические атаки и невозможность сконцентрироваться на чем то, рассеянность.
Все дело в токсинах, которые он вырабатывает. Они напрямую влияют на то, как мы себя морально чувствуем, и провоцируют искать замещение негативным эмоциям. чтобы испытать "кайф" через выброс дофамина.
Candida Albicans на самом деле вызывает недостаток серотонина и многие депрессивные состояния - причина грибка. Да, так просто! Ведь 70% серотонина вырабатывается именно в кишечнике. А вы это знали, или производители антидепрессантов молчат об этом?
Несомненно, антидепрессанты поднимают уровень серотонина, но ведь то же самое происходит, если вы отказываетесь от сахара!
Если вы едите много сладкого, скорее всего, у вас уже есть синдром дырявого кишечника. Чувствуете симптомы авитаминоза? Можно сказать почти с уверенность, что грибок захватил и продырявил ваш кишечник.
Если у вас в кишечнике живет разбушевавшаяся кандида, вы можете вести любой, самый здоровый, образ жизни, заниматься спортом, питаться идеально подобранным меню, но… ничего у вас не усвоится и тело будет страдать.
Что может быть хорошего, если Candida разрастается на стенках кишечника? Она буравит их, проедает, попадает в вашу кровь, разносится по всему организму.
Более того! Вместе с ней через повреждения в кровоток могут попадать и другие вещества. И, естественно, иммунная система начнет атаковать это, вызывая аутоиммунные заболевания.
Поэтому, если у вас аллергия, подумайте, нет ли у вас кандидоза?
ПОЧЕМУ ГОВОРЯТ, ЧТО ЭТОТ ГРИБОК ВЫЗЫВАЕТ ДЕПРЕССИЮ?
...А также панические атаки и невозможность сконцентрироваться на чем то, рассеянность.
Все дело в токсинах, которые он вырабатывает. Они напрямую влияют на то, как мы себя морально чувствуем, и провоцируют искать замещение негативным эмоциям. чтобы испытать "кайф" через выброс дофамина.
Candida Albicans на самом деле вызывает недостаток серотонина и многие депрессивные состояния - причина грибка. Да, так просто! Ведь 70% серотонина вырабатывается именно в кишечнике. А вы это знали, или производители антидепрессантов молчат об этом?
Несомненно, антидепрессанты поднимают уровень серотонина, но ведь то же самое происходит, если вы отказываетесь от сахара!

КАКОВЫ СИМПТОМЫ ГРИБКА, КОТОРЫЙ РАЗБУШЕВАЛСЯ?
Если у вас неинвазивный кандидоз кишечника, вы не будете ощущать чего-то на самом деле катастрофического, а отметите такие явления, как:
Если у вас неинвазивный кандидоз кишечника, вы не будете ощущать чего-то на самом деле катастрофического, а отметите такие явления, как:
- дискомфортные ощущения в животе
- метеоризм (вздутие живота, газы)
- периодическая диарея (жидкий стул)
- различные проявления аллергии
- синдром раздраженного кишечника
- язвенная болезнь 12-перстной кишки
- язвенный колит
- повышенная температура
- боли в животе
- постоянная диарея
- потеря веса
- кровь в кале
- тошнота
- рвота
- горькая отрыжка
- Уберите из рациона его основную пищу - сахар
- Введите овощи, чтобы восстановить нужные бактерии
- Принимайте пробиотики
- Применяйте противогрибковые средства
- Использование препараты, содержащие живую микрофлору
- Проводите дезинтоксикацию сорбентами
Поделитесь этой страницей с друзьями:
2019 г. © Центр "Альфа - Омега ПЛЮС".
Все права защищены.
e-mail: info@alfa-omega.plus
Все права защищены.
e-mail: info@alfa-omega.plus
